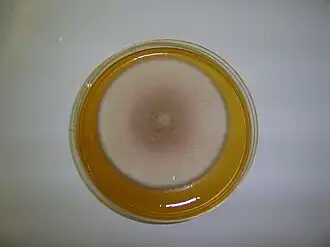
Description de cette image, également commentée ci-après

Paecilomyces
Paecilomyces
Culture de Paecilomyces sp. (sûrement Paecilomyces lilacinus).
| Règne | Fungi |
|---|---|
| Sous-règne | Dikarya |
| Division | Ascomycota |
| Sous-division | Pezizomycotina |
| Classe | Eurotiomycetes |
| Sous-classe | Eurotiomycetidae |
| Ordre | Eurotiales |
| Famille | Trichocomaceae |
Paecilomyces est un genre de mycètes (moisissures), dont un bon nombre d'espèces sont phytopathogènes.
Photos

Liste d'espèces
Selon Catalogue of Life (9 octobre 2019)[3] :
- Paecilomyces antarcticus Bridge, M. S. Clark & D. A. Pearce, 2005
- Paecilomyces aspergilloides Pidopl., 1950
- Paecilomyces atrovirens Z. Q. Liang & A. Y. Liu, 1993
- Paecilomyces baarnensis Fassat., 1967
- Paecilomyces borysthenicus B. A. Borisov & Tarasov, 1997
- Paecilomyces breviramosus Bissett, 1979
- Paecilomyces brunneolus (N. Inagaki) Samson & Houbraken, 2009
- Paecilomyces burci (Pollacci) Thom, 1930
- Paecilomyces byssochlamydoides Stolk & Samson, 1972
- Paecilomyces canadensis (Vuill.) A. H. S. Br. & G. Sm., 1957
- Paecilomyces cinnamomeus (Petch) Samson & W. Gams, 1974
- Paecilomyces clavisporus Hammill, 1970
- Paecilomyces cossus (Portier & Sartory) A. H. S. Br. & G. Sm., 1957
- Paecilomyces cremeoroseus Bat., 1957
- Paecilomyces cylindricosporus Z. Q. Liang & Y. F. Han, 2005
- Paecilomyces divaricatus (Thom) Samson, Houbraken & Frisvad, 2009
- Paecilomyces echinosporus M. J. Chen, G. H. Sung & B. Huang, 2011
- Paecilomyces erectus Demelius, 1923
- Paecilomyces fimetarius (Moesz) A. H. S. Br. & G. Sm., 1957
- Paecilomyces fulvus Stolk & E. S. Salmon, 1971
- Paecilomyces fuscatus N. Inagaki, 1962
- Paecilomyces gunnii Z. Q. Liang, 1985
- Paecilomyces hawkesii Z. M. Xiao, T. B. Li & Q. T. Chen, 1984
- Paecilomyces heliothis (Charles) A. H. S. Br. & G. Sm., 1957
- Paecilomyces hepiali Q.T. Chen & R.Q. Dai ex R.Q. Dai, X.M. Li, A.J. Shao, Shu F. Lin, J.L. Lan, Wei H. Chen & C.Y. Shen
- Paecilomyces huaxiensis Z. Q. Liang & Y. F. Han, 2005
- Paecilomyces indicus J. N. Rai, J. P. Tewari & Mukerji, 1969
- Paecilomyces isarioides N. Inagaki, 1962
- Paecilomyces laeensis Matsush., 1971
- Paecilomyces longipes (Petch) A. H. S. Br. & G. Sm., 1957
- Paecilomyces loushanensis Z. Q. Liang & A. Y. Liu, 1997
- Paecilomyces mandshuricus (Saito) Thom, 1930
- Paecilomyces maximus C. Ram, 1968
- Paecilomyces militaris Z. Q. Liang, 2001
- Paecilomyces musicola Matsush., 1975
- Paecilomyces niphetodes Samson, 1974
- Paecilomyces odonatae Zuo Y. Liu, Z. Q. Liang & A. Y. Liu, 1996
- Paecilomyces parvisporus Y. F. Han & Z. Q. Liang, 2006
- Paecilomyces pascuus Pitt & A. D. Hocking, 1985
- Paecilomyces penicillatus (Höhn.) Samson, 1974
- Paecilomyces persimplex (Kleb.) Delitsch & Henneberg, 1943
- Paecilomyces puntonii (Vuill.) Nann., 1934
- Paecilomyces purpureus Z. Q. Liang & Y. F. Han, 2007
- Paecilomyces ramosus Samson & H. C. Evans, 1974
- Paecilomyces rariramus Z. Q. Liang & Bo Wang, 2003
- Paecilomyces reniformis Samson & H. C. Evans, 1974
- Paecilomyces saturatus (Nakaz., Y. Takeda & Suematsu) Samson & Houbraken, 2009
- Paecilomyces simplex (Petch) A. H. S. Br. & G. Sm., 1957
- Paecilomyces smilanensis (Wize) A. H. S. Br. & G. Sm., 1957
- Paecilomyces stipitatus Z. Q. Liang & Y. F. Han, 2005
- Paecilomyces subglobosus Misaki, N. Yasui & Okabe, 1968
- Paecilomyces suffultus (Petch) Samson, 1974
- Paecilomyces tabacinus Jurjević, Hubka & S. W. Peterson, 2016
- Paecilomyces taitungiacus K. Y. Chen & Z. C. Chen, 1996
- Paecilomyces tenuis Y. F. Han & Z. Q. Liang, 2007
- Paecilomyces variotii Bainier, 1907
- Paecilomyces verrucosus Samson & Tansey, 1975
- Paecilomyces verticillatus Z. Q. Liang, Zhu Li & Y. F. Han, 2006
- Paecilomyces victoriae (Svilv.) A. H. S. Br. & G. Sm., 1957
- Paecilomyces vinaceus Y. F. Han & Z. Q. Liang, 2005
- Paecilomyces wawuensis Jin He, J. C. Kang & B. X. Lei, 2011
- Paecilomyces xylariiformis (Lloyd) Samson, 1974
- Paecilomyces zollerniae Stolk & Samson, 1971
Selon Index Fungorum (9 octobre 2019)[4] :
- Paecilomyces albus Demelius 1916
- Paecilomyces antarcticus Bridge, M.S. Clark & D.A. Pearce 2005
- Paecilomyces aspergilloides Pidopl. 1950
- Paecilomyces atrovirens Z.Q. Liang & A.Y. Liu 1993
- Paecilomyces aureocinnamomeus (Biourge) Thom 1930
- Paecilomyces austriacus Svilv. 1941
- Paecilomyces baarnensis Fassat. 1967
- Paecilomyces borysthenicus B.A. Borisov & Tarasov 1997
- Paecilomyces breviramosus Bissett 1979
- Paecilomyces brunneolus (N. Inagaki) Samson & Houbraken 2009
- Paecilomyces burcii (Pollacci) Thom 1930
- Paecilomyces byssochlamydoides Stolk & Samson 1972
- Paecilomyces canadensis (Vuill.) A.H.S. Br. & G. Sm. 1957
- Paecilomyces cinnamomeus (Petch) Samson & W. Gams 1974
- Paecilomyces clavisporus Hammill 1970
- Paecilomyces cossus (Portier & Sartory) A.H.S. Br. & G. Sm. 1957
- Paecilomyces cremeoroseus Bat. 1957
- Paecilomyces cylindricosporus Z.Q. Liang & Y.F. Han 2005
- Paecilomyces divaricatus (Thom) Samson, Houbraken & Frisvad 2009
- Paecilomyces echinosporus M.J. Chen, G.H. Sung & B. Huang 2011
- Paecilomyces erectus Demelius 1923
- Paecilomyces fimetarius (Moesz) A.H.S. Br. & G. Sm. 1957
- Paecilomyces fulvus Stolk & Samson 1971
- Paecilomyces fuscatus N. Inagaki 1962
- Paecilomyces griseoviridis M.X. Dai 1998
- Paecilomyces gunnii Z.Q. Liang 1985
- Paecilomyces hawkesii Z.M. Xiao, T.B. Li & Q.T. Chen 1984
- Paecilomyces heliothis (Charles) A.H.S. Br. & G. Sm. 1957
- Paecilomyces hepiali Q.T. Chen & R.Q. Dai 1989
- Paecilomyces hepiali Q.T. Chen & R.Q. Dai ex R.Q. Dai, X.M. Li, A.J. Shao, Shu F. Lin, J.L. Lan, Wei H. Chen & C.Y. Shen 2008
- Paecilomyces hibernicus Kennelly & Grimes 1930
- Paecilomyces huaxiensis Z.Q. Liang & Y.F. Han 2005
- Paecilomyces indicus J.N. Rai, J.P. Tewari & Mukerji 1969
- Paecilomyces isarioides N. Inagaki 1962
- Paecilomyces laeensis Matsush. 1971
- Paecilomyces longipes (Petch) A.H.S. Br. & G. Sm. 1957
- Paecilomyces loushanensis Z.Q. Liang & A.Y. Liu 1997
- Paecilomyces mandshuricus (Saito) Thom 1930
- Paecilomyces maximus C. Ram 1968
- Paecilomyces militaris Z.Q. Liang 2001
- Paecilomyces musicola Matsush. 1975
- Paecilomyces niphetodes Samson 1974
- Paecilomyces odonatae Zuo Y. Liu, Z.Q. Liang & A.Y. Liu 1996
- Paecilomyces parvisporus Y.F. Han & Z.Q. Liang 2006
- Paecilomyces pascuus Pitt & A.D. Hocking 1985
- Paecilomyces penicillatus (Höhn.) Samson 1974
- Paecilomyces persimplex (Kleb.) Delitsch & Henneberg 1943
- Paecilomyces puntonii (Vuill.) Nann. 1934
- Paecilomyces purpureus Z.Q. Liang & Y.F. Han 2007
- Paecilomyces ramosus Samson & H.C. Evans 1974
- Paecilomyces rariramus Z.Q. Liang & Bo Wang 2003
- Paecilomyces saturatus (Nakaz., Y. Takeda & Suematsu) Samson & Houbraken 2009
- Paecilomyces simplex (Petch) A.H.S. Br. & G. Sm. 1957
- Paecilomyces smilanensis (Wize) A.H.S. Br. & G. Sm. 1957
- Paecilomyces stipitatus Z.Q. Liang & Y.F. Han 2005
- Paecilomyces subflavus Svilv. 1941
- Paecilomyces subglobosus Misaki, N. Yasui & Okabe 1968
- Paecilomyces suffultus (Petch) Samson 1974
- Paecilomyces tabacinus Jurjević, Hubka & S.W. Peterson 2016
- Paecilomyces taitungiacus K.Y. Chen & Z.C. Chen 1996
- Paecilomyces tenuis Y.F. Han & Z.Q. Liang 2007
- Paecilomyces variotii Bainier 1907
- Paecilomyces verrucosus Samson & Tansey 1975
- Paecilomyces verticillatus Z.Q. Liang, Zhu Li & Y.F. Han 2006
- Paecilomyces victoriae (Svilv.) A.H.S. Br. & G. Sm. 1957
- Paecilomyces vinaceus Y.F. Han & Z.Q. Liang 2005
- Paecilomyces viridulus Tzean, J.L. Chen, L.S. Hsieh & J.C. Peng 1990
- Paecilomyces wawuensis Jin He, J.C. Kang & B.X. Lei 2011
- Paecilomyces xylariiformis (Lloyd) Samson 1974
- Paecilomyces zollerniae Stolk & Samson 1971
Notes et références
Références taxinomiques
- (en) BioLib : Paecilomyces Bainier (consulté le )
- (en) Catalogue of Life : Paecilomyces (consulté le )
- (en) Index Fungorum : Paecilomyces Bainier 1907 (+ liste espèces) (+ MycoBank) (consulté le )
- (en) MycoBank : Paecilomyces Bainier (consulté le )
- (en) NCBI : Paecilomyces (taxons inclus) (consulté le )
- Portail de la mycologie